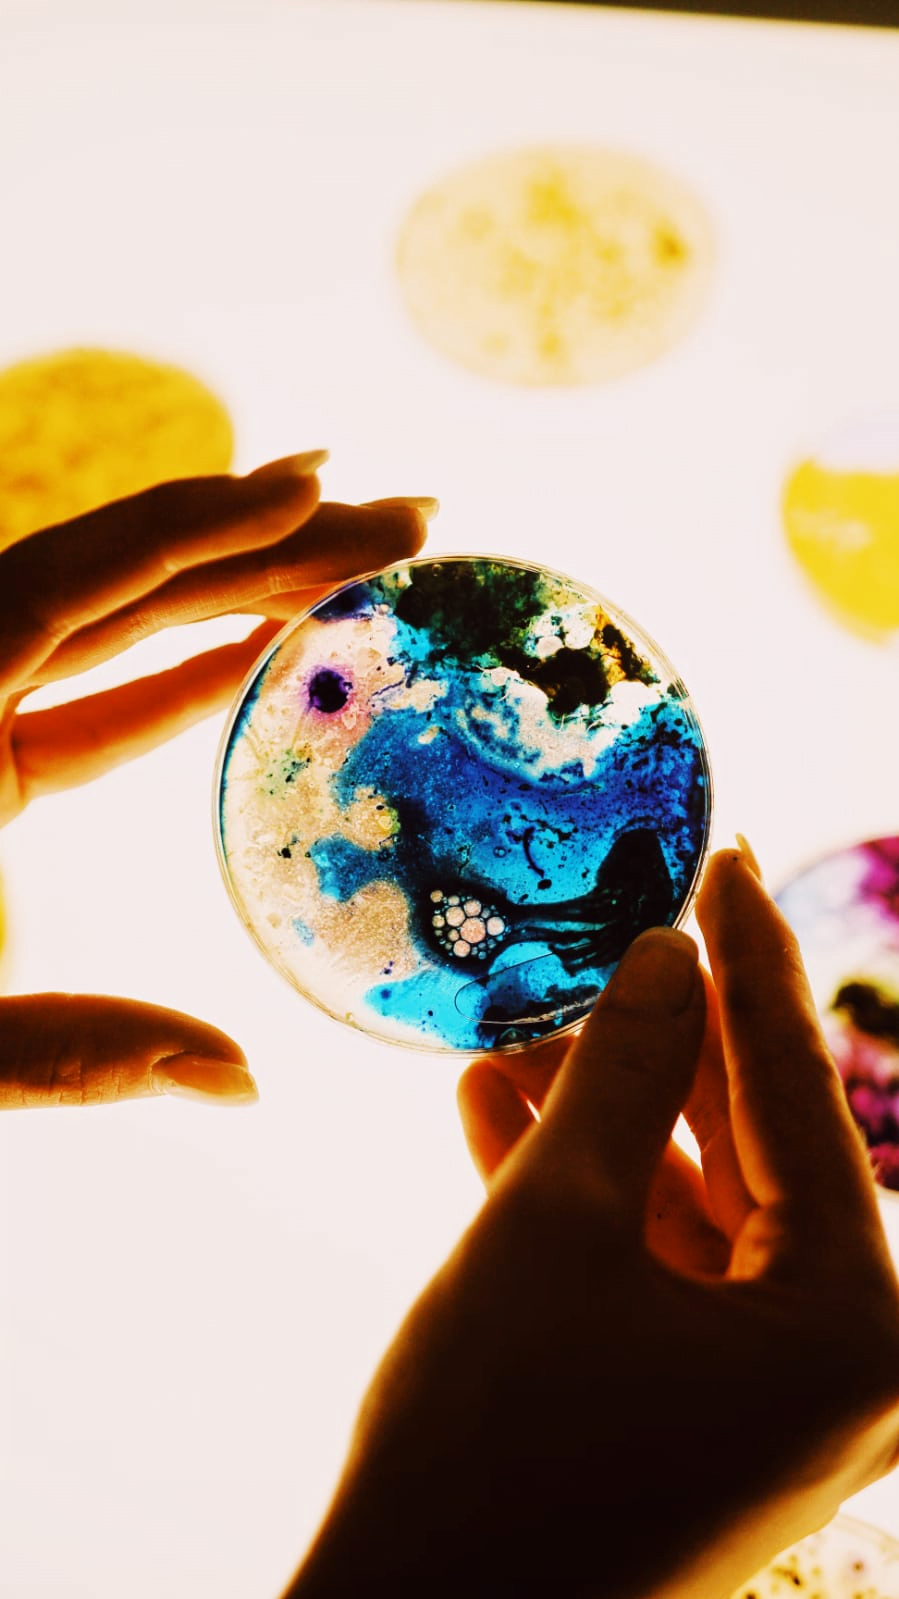
Imagen 2

¡Tu carrito está actualmente vacío!

¿Te inspira la naturaleza y quieres descubrir cómo integrarla en el arte y en el diseño?
¿Te gustaría adaptar tu proyecto a la creciente demanda de la sostenibilidad?
Nuestros Talleres Intensivos se adaptan tanto a principiantes como a personas con más experiencia.

| viernes: |
| 17:00H – 19:30H |
*Curso de tres meses. Duración por taller: 2h y 30min. Todos los Viernes.
☏ Escríbenos por WhatsApp para saber la disponibilidad para apuntarte a los Talleres Intensivos.
TODOS LOS DERECHOS RESERVADOS.